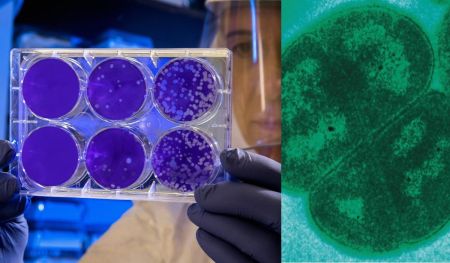

Паперові купюри та монети щодня проходять через сотні рук і накопичують велику кількість мікроорганізмів. Медики пояснили, які бактерії та віруси…
бактерії
В Іспанії досліджують незвичайні кислотні озера, де життя існує в умовах, які більшість організмів не витримала б. Вчені вважають, що…
Дослідники з’ясували, що туман є не просто скупченням водяних крапель. У ньому живуть мільйони бактерій, частина яких здатна поглинати токсичні…
У мексиканській пустелі Чіуауа розташована одна з найдивовижніших природних пам’яток світу — печера кристалів у шахті Найка. Саме тут вчені…
Багаторазові пляшки для води та трубочки без регулярного миття можуть накопичувати бактерії й становити ризик для здоров’я. Фахівці попереджають, що…
Дослідники швейцарського інституту Empa розробили революційний наноматеріал на основі графену, здатний нейтралізувати небезпечні лікарняні патогени. Унікальність технології полягає в тому,…
Більшість людей впевнені: найбрудніше місце у ванній — це унітаз. Проте дослідження показують, що справжній «лідер» за кількістю бактерій —…
У мангровому болоті на острові Гваделупа науковці виявили найбільші бактерії з відомих науці — настільки великі, що їх можна побачити неозброєним оком. Незвичайний організм знайшли ще 2009 року під час…
Нещодавно дослідники протестували два добре вивчені лабораторні віруси на звичайних матеріалах, аби зрозуміти, що відбувається, коли вони залишаються на поверхні.…
Мікробіом шлунково-кишкового тракту має настільки потужний вплив на фізичний та психоемоційний стан людини, що його нерідко називають «другим мозком». Усередині…
Одяг з секонд-хенду може становити загрозу для здоров’я, якщо його не обробити належним чином. Як зазначають експерти, навіть після прання…
Земні бактерії здебільшого не пристосовані для виживання в екстремальних космічних умовах. Однак, нещодавно дослідники знайшли вид мікроорганізмів, здатних до цього. Як пише видання Live…
Супербактерії (стійкі до антибіотиків бактерії) є одними з найсерйозніших небезпек для здоров’я населення в наш час. Вони здатні мутувати, щоб протистояти навіть…
Бактерія Deinococcus radiodurans є однією з найстійкіших бактерій на Землі. Вона здатна витримати рівень радіації, який у 28 000 разів перевищує…
Провідні вчені світу закликали припинити дослідження “дзеркальних бактерій”, які були створені у лабораторії. Експерти попереджають, що ці організми, сформовані з дзеркальних відображень…
Бактерії у нашому житті пов’язані з брудом та можуть бути небезпечними. Саме тому ми приділяємо багато уваги прибиранню, але чи…
Вчені зробили значний крок уперед у боротьбі зі стійкими до антибіотиків бактеріями, розробивши інноваційний шкірний пластир. Цей пластир використовує слабкі електричні струми для…
У Валенсії (Іспанія) мати об’єдналася разом з донькою, аби реставрувати фрески у церкві Сантос Хуанес за допомогою бактерій. Коли у матері почалися…
Дослідники з Північно-Західного університету США знайшли рішення, яке може допомогти в боротьбі зі зростаючою проблемою забруднення пластиком навколишнього середовища. Вони ідентифікували…
Дослідники з Університету Кейо в Токіо і Широкого інституту Массачусетського технологічного інституту та Гарварду виявили групу з 18 штамів бактерій,…